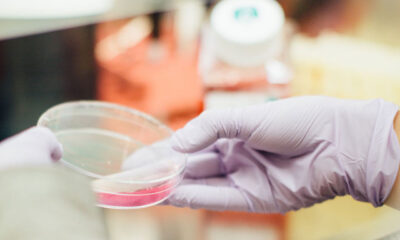
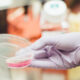

Prenderà il via lunedì 19 aprile, dopo la “prova” dei giorni scorsi in piazza Magnago, a Bolzano, l’azione “Testiamoci”. Passo dopo passo, a seconda dell’adesione dei...


Dopo lo screening avvenuto lo scorso fine settimana nei comuni di Brunico, Predoi e Selva dei Molini, ora toccherà a Gais, Valle Aurina e Curon sottoporsi a...


Ultime ore per il progetto Test rapidi in Alto Adige. Dopo che nello scorso fine settimana lo screening diffuso si è svolto in tutti i 116...


“Dopo molte settimane di dati deludenti e preoccupanti, finalmente un successo che restituisce fiducia. L’Alto Adige ha dimostrato grande senso civico“. Questo il ringraziamento che il...


E’ cominciato oggi (20 novembre) il piano di screening di massa per il rilievo del contagio da Covid-19 in Alto Adige. Fino a domenica, dalle 8...

Il Comitato Interprofessionale della Provincia Autonoma di Bolzano invita tutti gli iscritti agli Ordini e Collegi tecnici a partecipare allo screening di massa per il contenimento...


Test a tappeto a partire dalla fine di novembre (presumibilmente intorno al 20) per verificare il grado di diffusione del contagio in Alto Adige. E’ quanto...